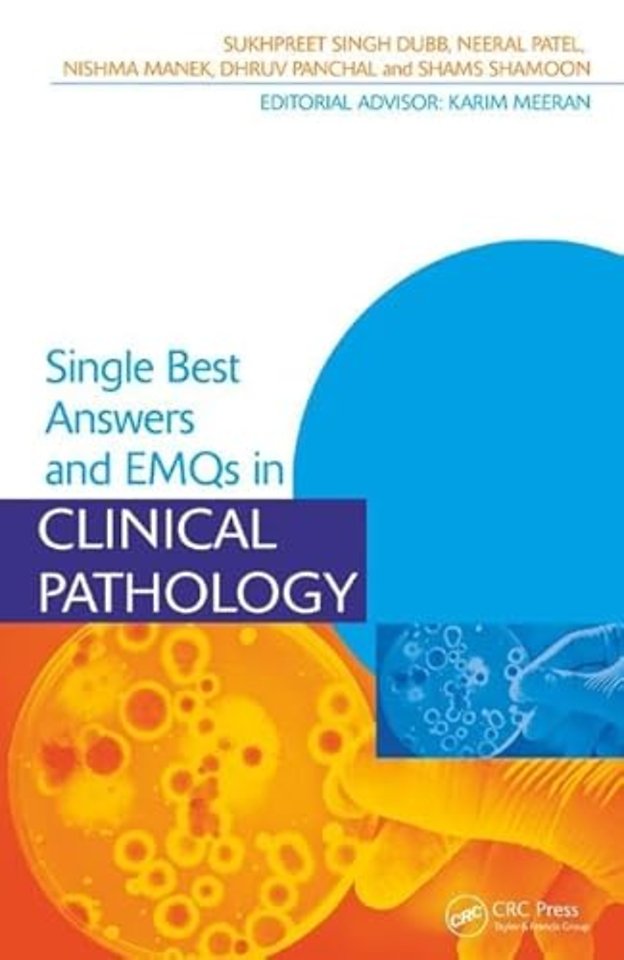
Single Best Answers and EMQs in Clinical Pathology

Single Best Answers and EMQs in Clinical Pathology
Samenvatting
This book presents 200 single best answer-style and 50 extended matching question-style questions arranged by sub-specialty area as well as a practice exam of random questions. It provides medical students with a useful source for exam revision as well as supplementing their knowledge.